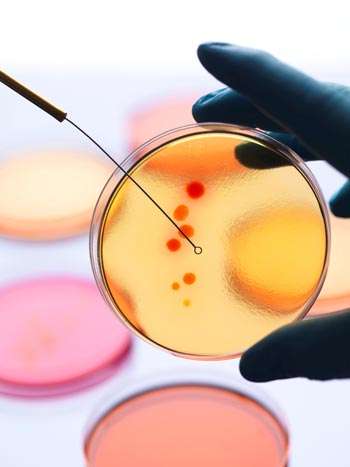
Glove holding petri dish

Research
Find your care
Our knowledgeable experts treat obesity and fatty liver disease while improving metabolic health. Call 310-825-2631 to connect with a specialist.
The answer is not always as simple as we eat too much and exercise too little. Science is now starting to offer deeper insights in the the obesity prevalence in the United States.
At the Center for Obesity and METabolic Health (COMET), our researchers are investigating obesity from nutrient contribution to obesity, how alterations of lipid metabolism promote liver damage and insulin resistance/diabetes, the role that the brain activity -related to appetite, eating habits and food preferences -plays in weight loss after bariatric surgery and more.